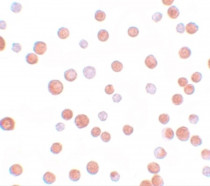

ARG41087
anti-TCF12 antibody
anti-TCF12 antibody for ICC/IF,Western blot and Human
Overview
| Product Description | Rabbit Polyclonal antibody recognizes TCF12 |
|---|---|
| Tested Reactivity | Hu |
| Tested Application | ICC/IF, WB |
| Host | Rabbit |
| Clonality | Polyclonal |
| Isotype | IgG |
| Target Name | TCF12 |
| Antigen Species | Human |
| Immunogen | A 19 amino acid peptide within aa. 50 - 100 of Human TCF12. |
| Conjugation | Un-conjugated |
| Alternate Names | Transcription factor 12; HEB; Transcription factor HTF-4; E-box-binding protein; DNA-binding protein HTF4; Class B basic helix-loop-helix protein 20; CRS3; HsT17266; HTF4; TCF-12; bHLHb20 |
Application Instructions
| Application Suggestion |
|
||||||
|---|---|---|---|---|---|---|---|
| Application Note | * The dilutions indicate recommended starting dilutions and the optimal dilutions or concentrations should be determined by the scientist. |
Properties
| Form | Liquid |
|---|---|
| Purification | Affinity purification with immunogen. |
| Buffer | PBS and 0.02% Sodium azide. |
| Preservative | 0.02% Sodium azide |
| Concentration | 1 mg/ml |
| Storage Instruction | For continuous use, store undiluted antibody at 2-8°C for up to a week. For long-term storage, aliquot and store at -20°C or below. Storage in frost free freezers is not recommended. Avoid repeated freeze/thaw cycles. Suggest spin the vial prior to opening. The antibody solution should be gently mixed before use. |
| Note | For laboratory research only, not for drug, diagnostic or other use. |
Bioinformation
| Database Links | |
|---|---|
| Gene Symbol | TCF12 |
| Gene Full Name | transcription factor 12 |
| Background | The protein encoded by this gene is a member of the basic helix-loop-helix (bHLH) E-protein family that recognizes the consensus binding site (E-box) CANNTG. This encoded protein is expressed in many tissues, among them skeletal muscle, thymus, B- and T-cells, and may participate in regulating lineage-specific gene expression through the formation of heterodimers with other bHLH E-proteins. Several alternatively spliced transcript variants of this gene have been described, but the full-length nature of some of these variants has not been determined. [provided by RefSeq, Jul 2008] |
| Function | Transcriptional regulator. Involved in the initiation of neuronal differentiation. Activates transcription by binding to the E box (5'-CANNTG-3'). [UniProt] |
| Cellular Localization | Nucleus. [UniProt] |
| Calculated MW | 73 kDa |
Images (2) Click the Picture to Zoom In